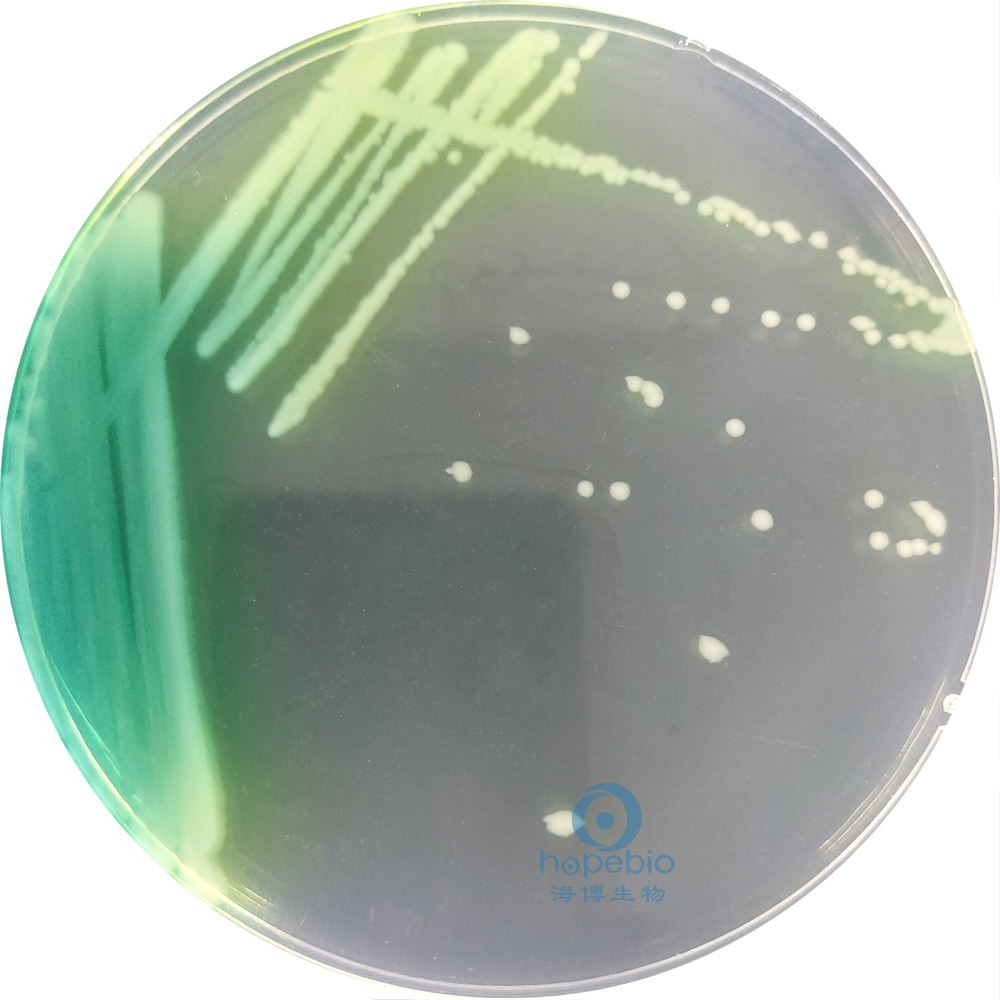
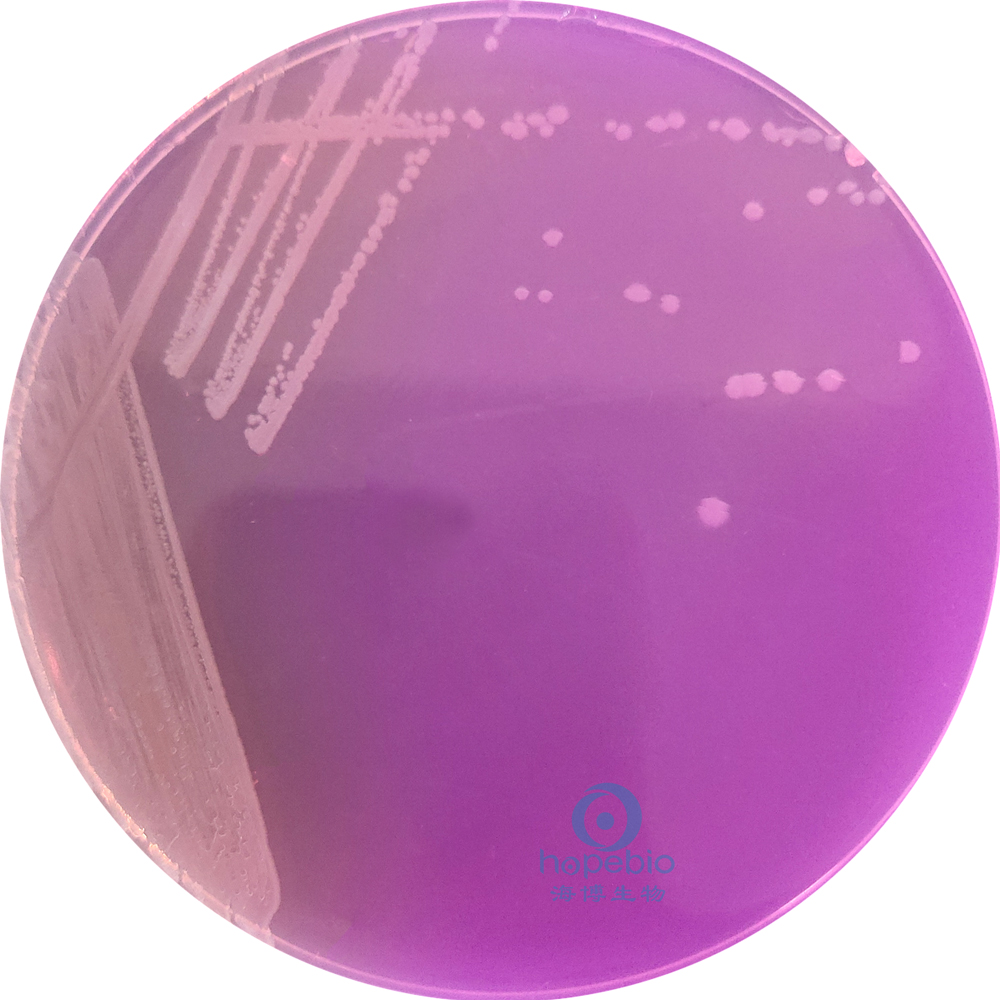

海博微信公众号
海博微信公众号
 海博天猫旗舰店
海博天猫旗舰店


 海博微信公众号
海博微信公众号
 海博天猫旗舰店
海博天猫旗舰店




一、简介
铜绿假单胞菌(Pseudomonas aeruginosa)属于假单胞菌属,为革兰氏阴性杆菌,氧化酶阳性,能产生绿脓菌素。此外还能液化明胶,还原硝酸盐为亚硝酸盐,在42℃±1℃条件下能生长。
铜绿假单胞菌在自然界分布甚广,空气、水、土壤中均有存在。对人有致病力,常引起人皮肤化脓感染,特别是烧伤、烫伤、眼部疾病患者被感染后,常使病情恶化,并可引起败血症,因此,在化妆品卫生标准中规定不得检出铜绿假单胞菌。
二、参考标准
《化妆品安全技术规范》(2015年版)
三、检验流程
1.增菌培养
取样品稀释液加到SCDLP液体培养基中,置36℃±1℃培养18h-24h。如有铜绿假单胞菌生长,培养液表面多有一层薄菌膜,培养液常呈黄绿色或蓝绿色。结果如图1所示:

a:空白对照;b:铜绿假单胞菌
图1 SCDLP液体培养基培养结果
2.分离培养
从培养液的薄膜处挑取培养物,划线接种在溴化十六烷基三甲铵琼脂平板上,置36℃±1℃培养18h-24h。
铜绿假单胞菌生长过程中会产生两种水溶性色素:黄色的荧光素和绿色的绿脓菌素,所以在溴化十六烷基三甲铵琼脂平板上菌落呈黄绿色。铜绿假单胞菌在此培养基上,其菌落扁平无定型,向周边扩散或略有蔓延,表面湿润,菌落呈灰白色,菌落周围培养基常扩散有水溶性色素。结果如图2所示:
图2 铜绿假单胞菌在溴化十六烷基三甲铵琼脂上的培养结果
在缺乏溴化十六烷基三甲铵琼脂时也可用乙酰胺培养基进行分离,将菌液划线接种于平板上,置36℃±1℃培养24h±2h。
铜绿假单胞菌在此培养基上生长良好,菌落扁平,边缘不整,菌落周围培养基呈红色,其他菌不生长。结果如图3所示:
图3 铜绿假单胞菌在乙酰胺培养基上的培养结果
3.染色镜检
挑取可疑的菌落,涂片,革兰氏染色,镜检结果为革兰氏阴性者应进行氧化酶试验。铜绿假单胞菌为革兰氏阴性无芽胞杆菌,呈红色杆状。结果如图4所示:

图4 铜绿假单胞菌的革兰氏染色结果
4.氧化酶试验
用无菌玻璃棒挑取铜绿假单胞菌可疑菌落涂在氧化酶试纸上,在30s内变为蓝色或蓝紫色为阳性,2min内不变色为阴性。铜绿假单胞菌在氧化酶试纸上显蓝色,为阳性。结果如图5所示:

a:铜绿假单胞菌;b:大肠埃希氏菌
图5 氧化酶试验结果
5.绿脓菌素试验
取可疑菌落2-3个,分别接种在绿脓菌素测定培养基上,置36℃±1℃培养24h±2h,结果如图6所示;向试管中加入氯仿3-5mL,充分振荡使培养物中的绿脓菌素溶解于氯仿液内,待氯仿提取液呈蓝色时,用吸管将氯仿移到另一试管中并加入1 mol/L的盐酸1mL左右,振荡后,静置片刻。如上层盐酸液内出现粉红色到紫红色时为阳性,表示被检物中有绿脓菌素存在,结果如图7所示:

a:空白对照;b:大肠埃希氏菌;c:铜绿假单胞菌
图6 绿脓菌素测定培养基培养结果

a:大肠埃希氏菌;b:铜绿假单胞菌
图7 绿脓菌素试验结果
6.硝酸盐还原产气试验
挑取可疑的铜绿假单胞菌纯培养物,接种在硝酸盐胨水培养基中,置36℃±1℃培养24h±2h,观察结果。
铜绿假单胞菌在硝酸盐胨水培养基内的小倒管中有气体,即为阳性,表明该菌能还原硝酸盐,并将亚硝酸盐分解产生氮气。结果如图8所示:

a:空白对照;b:大肠埃希氏菌;c:铜绿假单胞菌
图8 硝酸盐还原产气试验结果
7.明胶液化试验
取铜绿假单胞菌可疑菌落的纯培养物,穿刺接种在明胶培养基内,置36℃±1℃培养24h±2h,取出放置于4℃±2℃冰箱10-30min,观察结果。
呈溶解状或表面溶解时即为明胶液化试验阳性;如凝固不溶者为阴性。铜绿假单胞菌呈溶解状态,为阳性。结果如图9所示:

a:空白对照;b:接菌培养后;c:铜绿假单胞菌4℃放置后;d:大肠埃希氏菌4℃放置后
图9 明胶液化试验结果
8.42℃生长试验
挑取可疑的铜绿假单胞菌纯培养物,接种在普通琼脂斜面培养基上,置于42℃±1℃培养箱中,培养24h-48h。铜绿假单胞菌能生长,为阳性,而近似的荧光假单胞菌则不能生长。结果如图10所示:

a:空白对照;b:铜绿假单胞菌
图10 普通琼脂斜面培养基培养结果
9.检验结果报告
被检样品经增菌分离培养后,经证实为革兰氏阴性杆菌,氧化酶及绿脓菌素试验皆为阳性者,即可报告被检样品中检出铜绿假单胞菌;如绿脓菌素试验阴性而液化明胶、硝酸盐还原产气、42℃生长试验三者皆为阳性时,仍可报告被检样品中检出铜绿假单胞菌。
注:本文属海博生物原创,未经允许不得转载。
上一篇:叶酸测定培养基试验方法及注意事项



